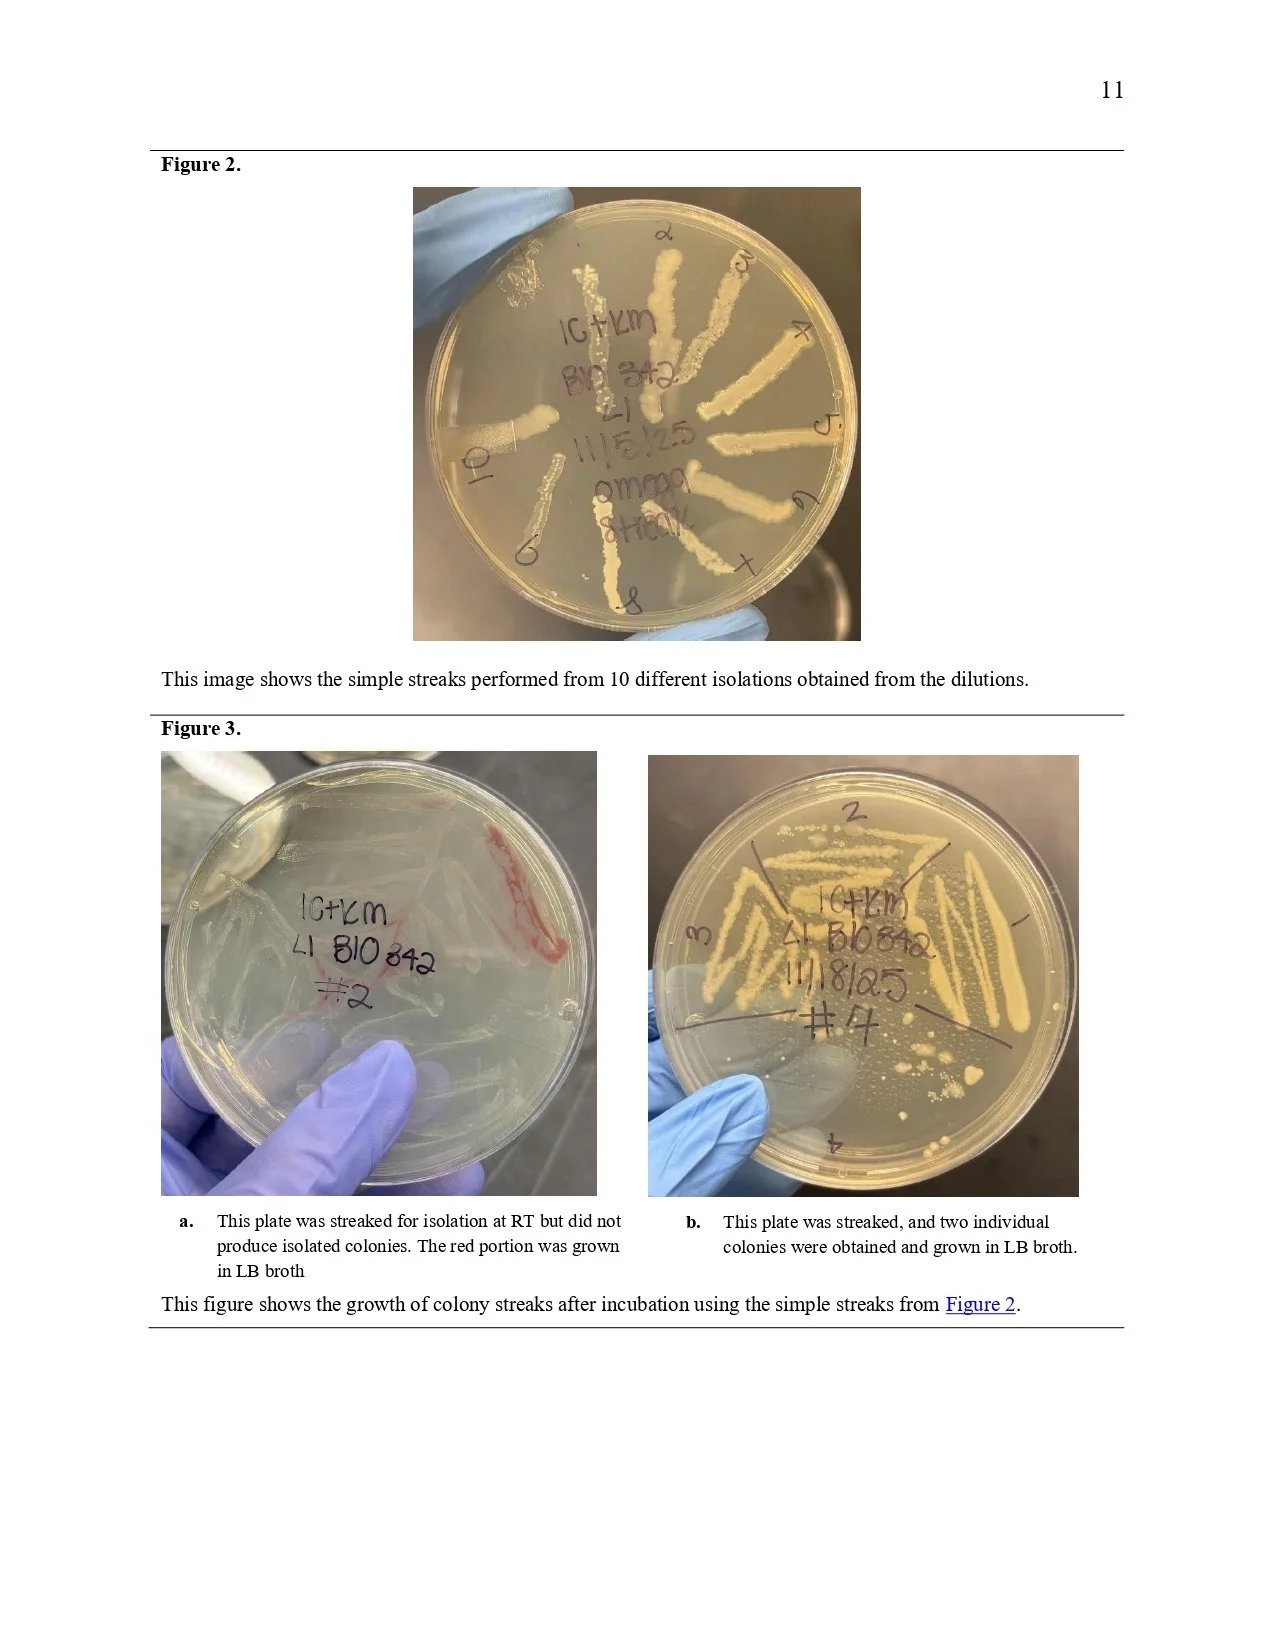
Unknown Paper _page-0011.jpg
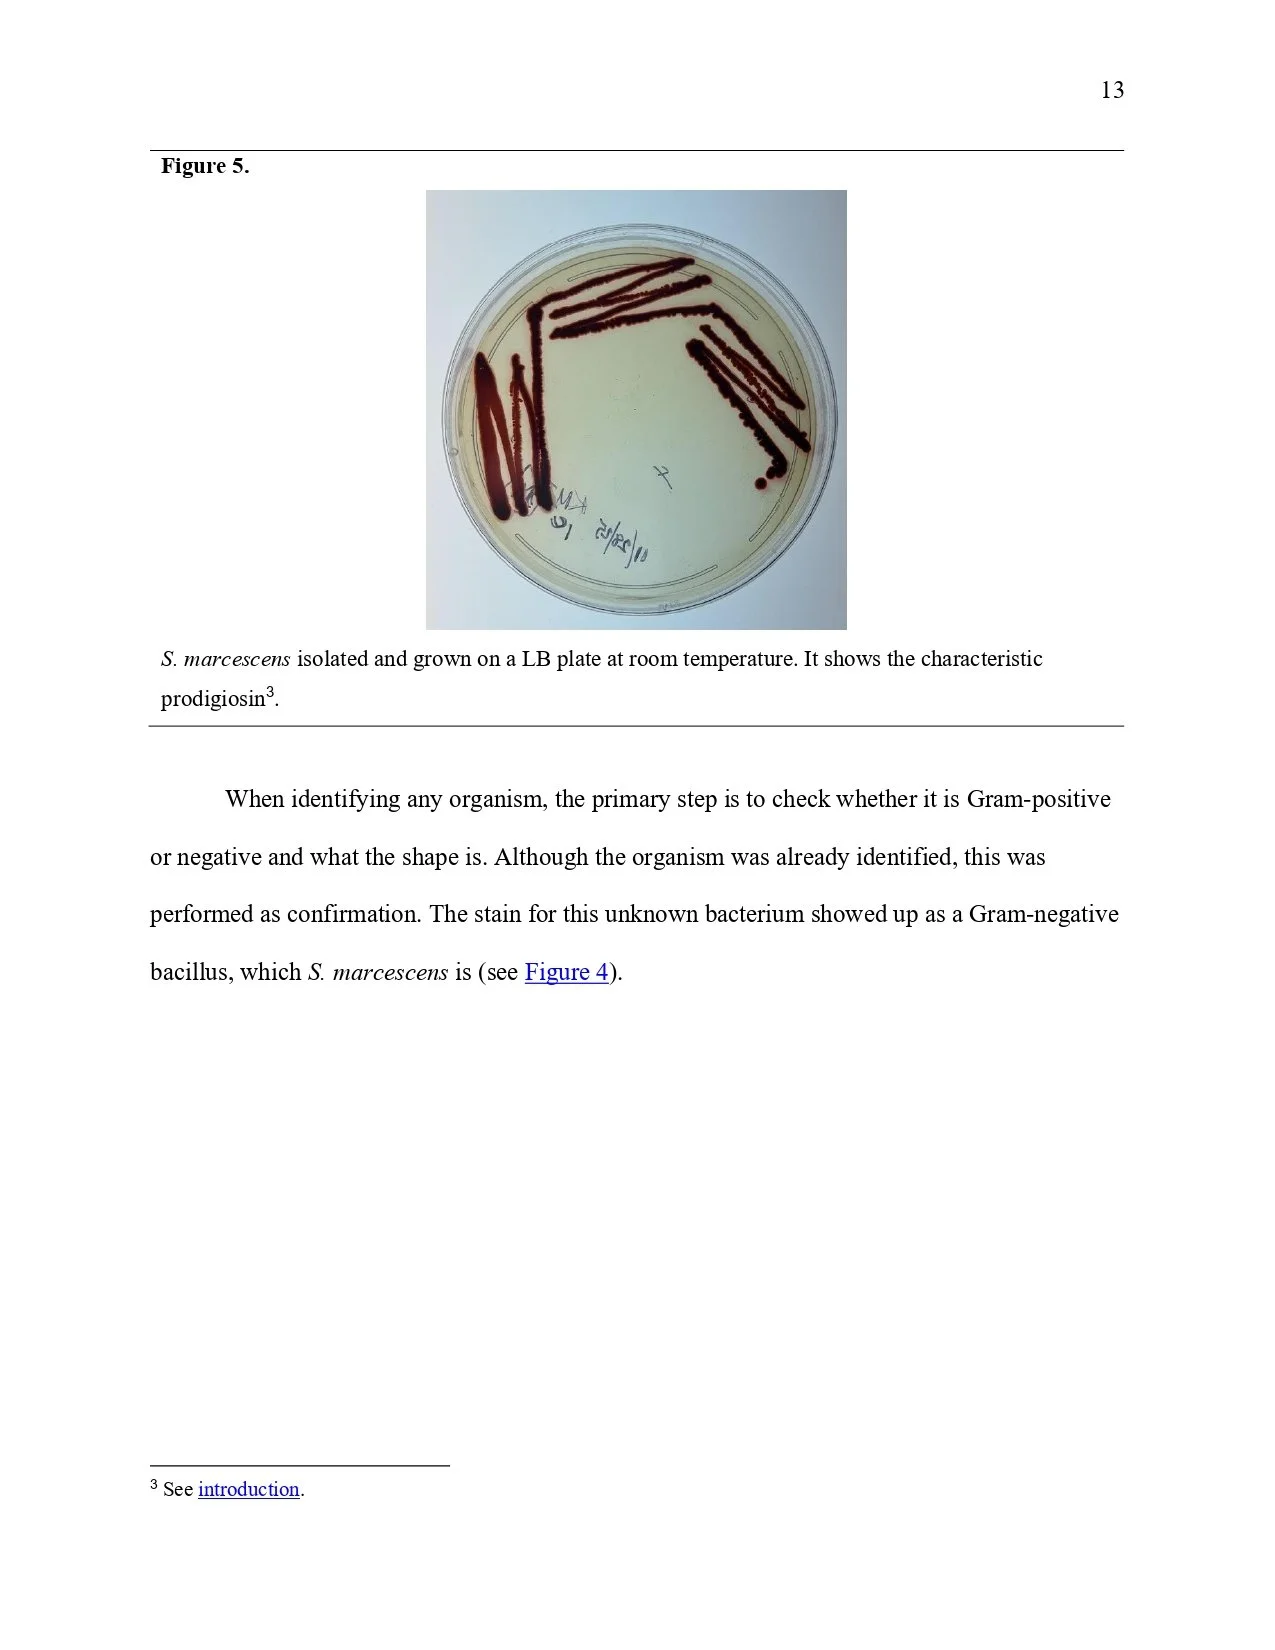
Unknown Paper _page-0013.jpg
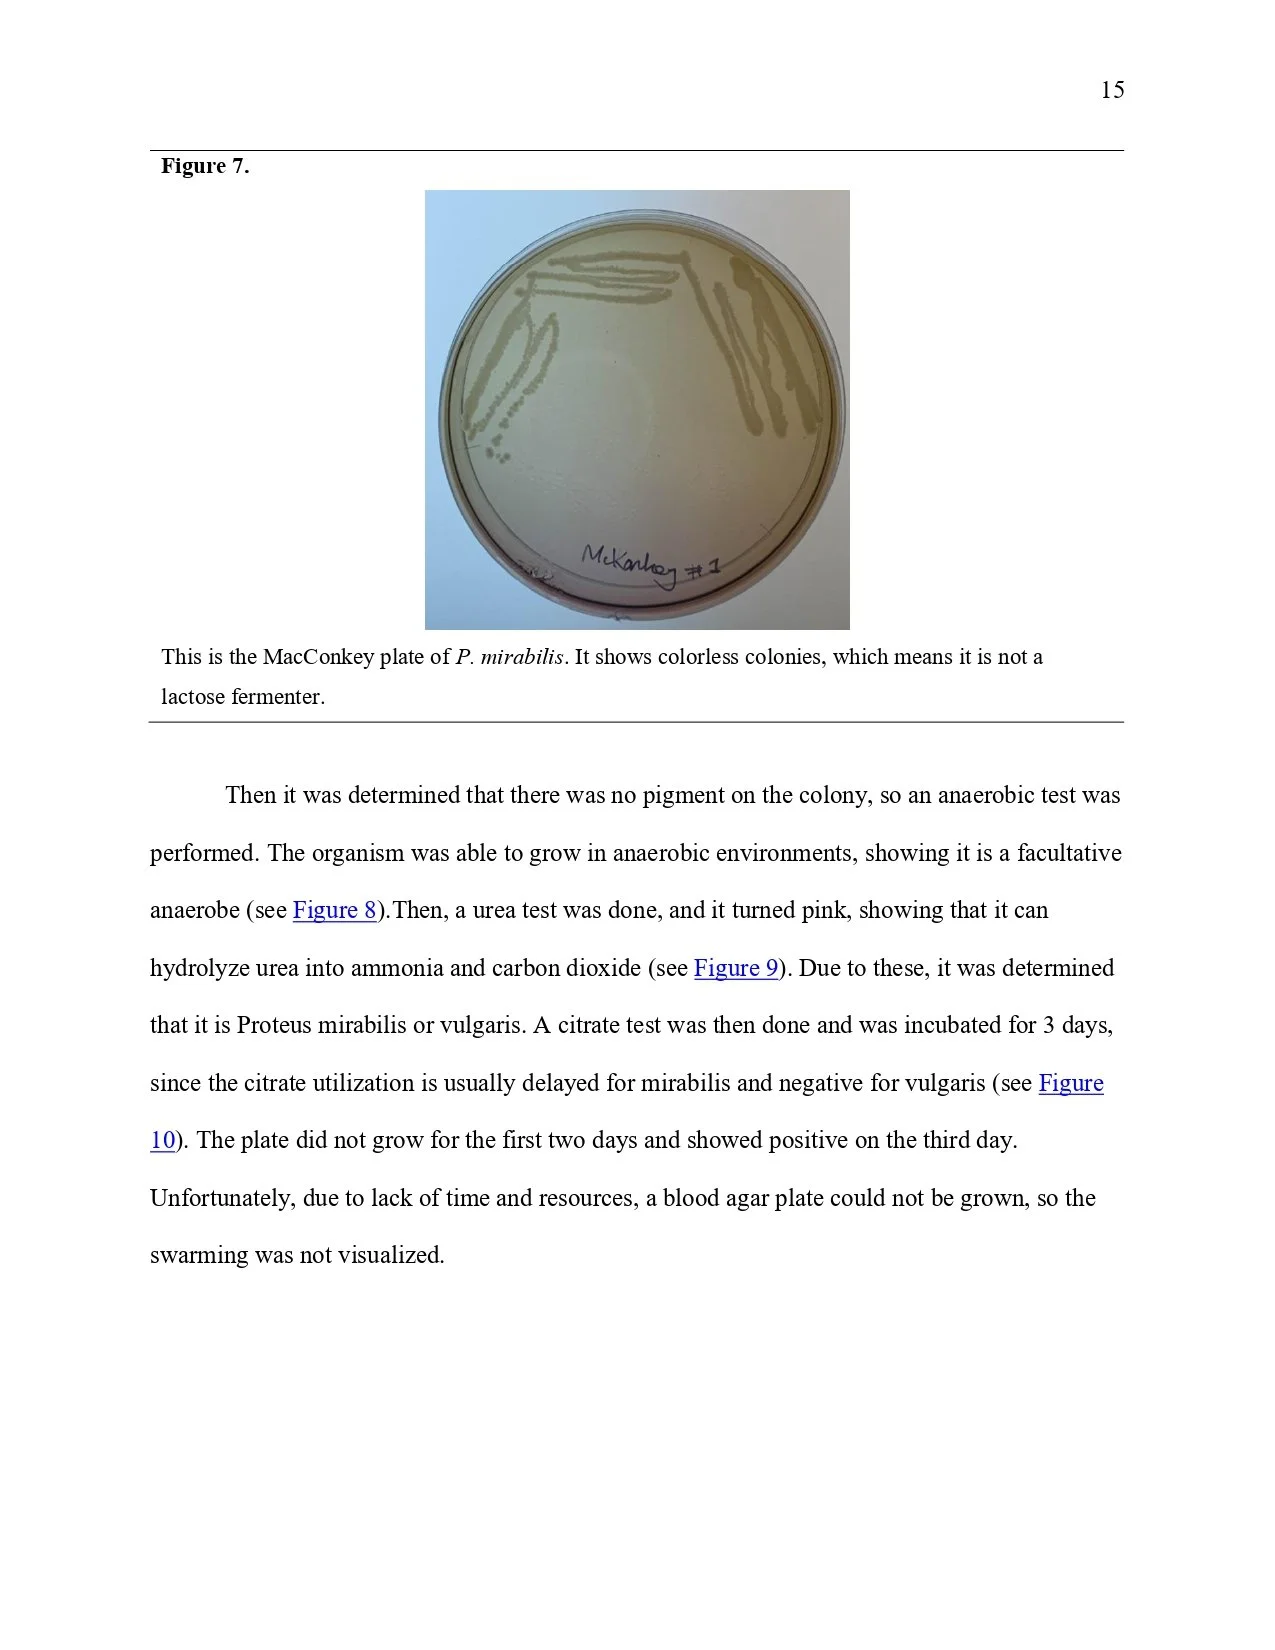
Unknown Paper _page-0015.jpg
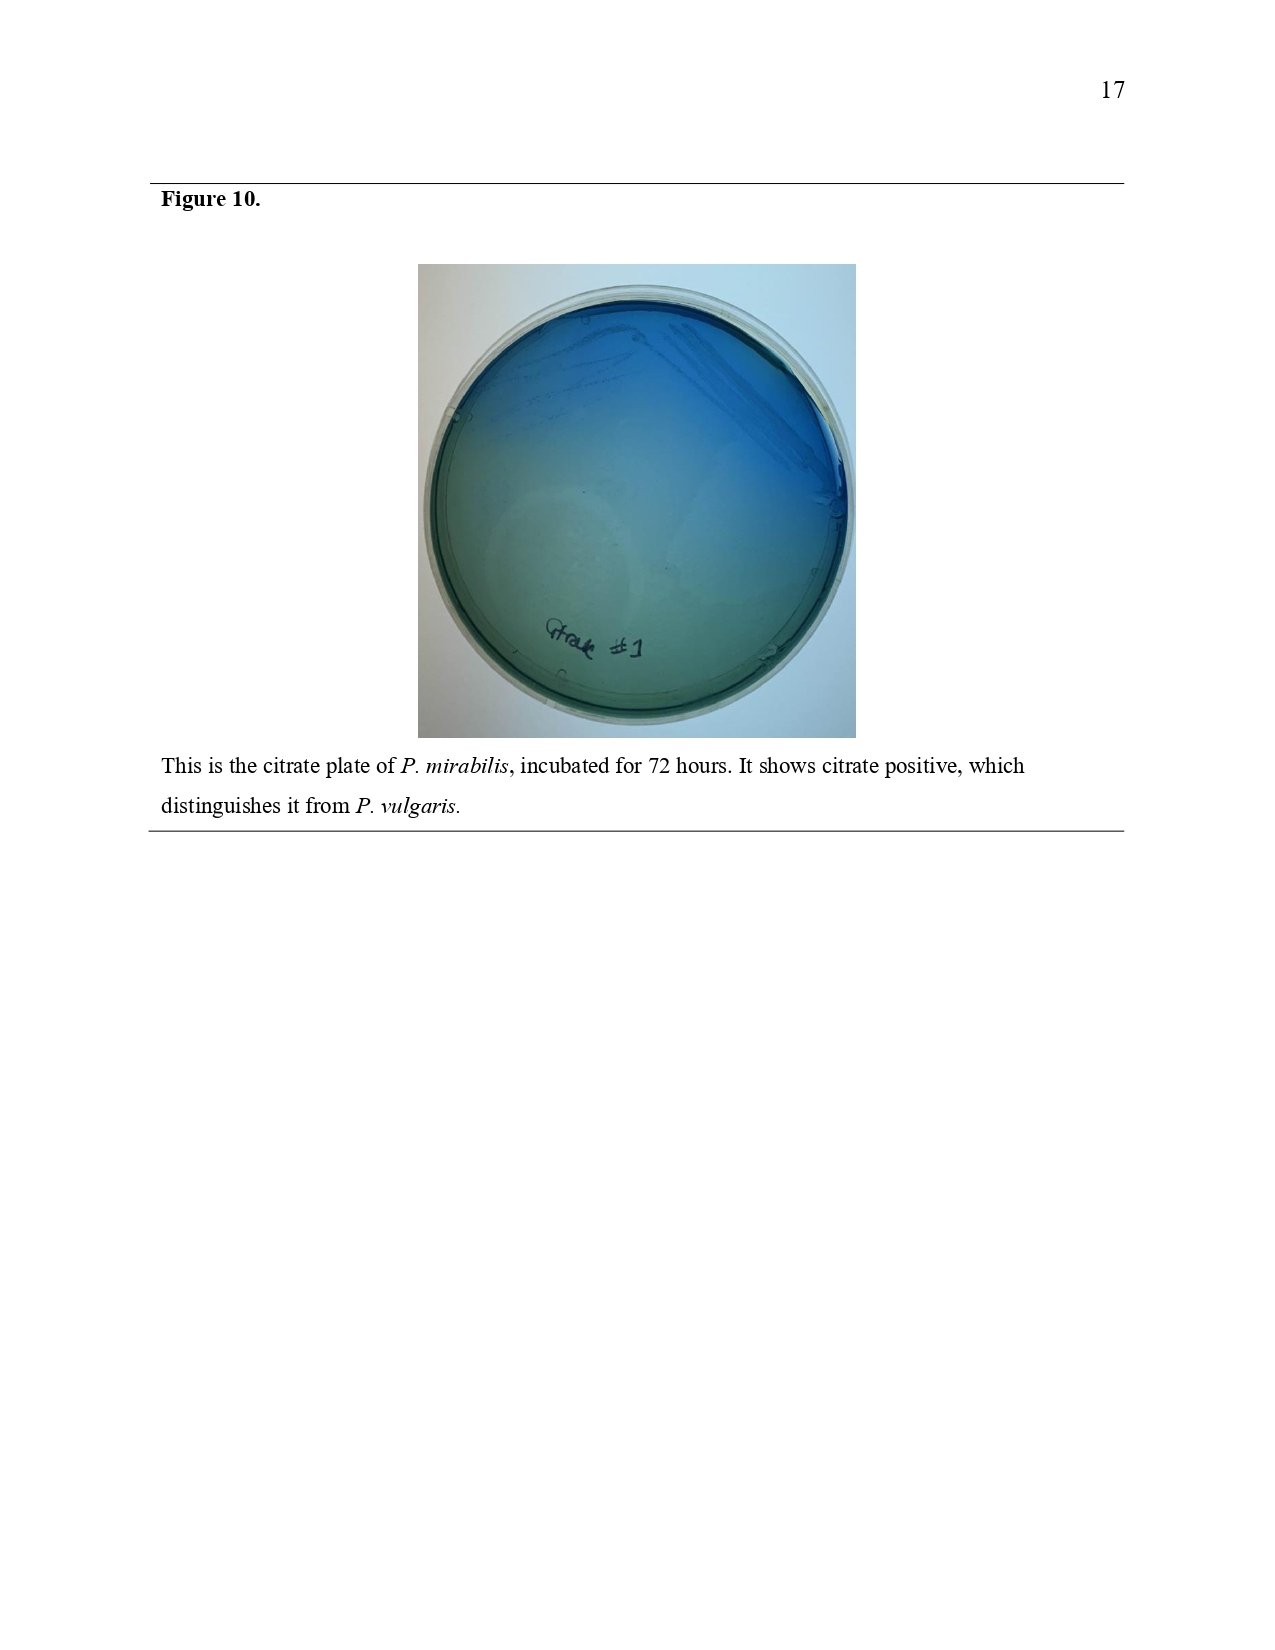
Unknown Paper _page-0017.jpg

Unknown Lab Project Clinical Microbiology
I created a flowchart to determine exactly which bacteria existed using the source below. I did this by looking at the identification criteria for each bacterium, placing them in a spreadsheet, sorting by test type, identifying which test type was closest to 50/50 for each pair of results, splitting the bacteria into the two categories, and repeating for each category. Once there were no tests to distinguish between them, I would use the morphology of the colony to specify. If they still cannot be determined even with morphology, I would group them together.
Bibliography
Garrity, G. M., Brenner, D. J., Krieg, N. R., & Staley, J. T. (2005). Bergey’s manual of systematic bacteriology (Second ed). Springer.